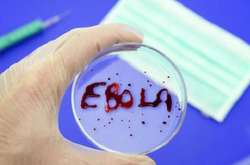
В Африку повернулася лихоманка Ебола

Демократическая республика Конго

Для Демократичної Республіки Конго це вже сімнадцятий спалах вірусу Ебола в історії
28 травня, 18:48

Угода має доповнитися економічними та видобувними проєктами, що зблизять країни
5 грудня, 2025 02:40

У Конго на копальні загинули шахтарі
17 листопада, 2025 10:38

Наразі адміністрація Трампа виступає посередником у мирних переговорах між Конго та Руандою
10 листопада, 2025 23:51

Раніше артистка намагалась отримати візу, аби прилетіти до родича в Африку
22 вересня, 2025 09:19

Бойовики також атакували сусіднє село Мачонгані, де загинули щонайменше п’ятеро людей
28 липня, 2025 05:02

Небезпечну інфекцію у Конго передають в основному блохи
7 травня, 2025 10:37

Із вʼязниці Мунзензе в Гомі втекли близько 4 тис. увʼязнених, більшість яких чоловіки
6 лютого, 2025 10:33

ВООЗ: понад 30 людей загинули від невідомої хвороби у Конго
9 грудня, 2024 12:59

Посольство України в Конго офіційно розпочало роботу 10 квітня
11 квiтня, 2024 08:25

Найближчим часом відбудеться офіційне відкриття дипломатичних установ України у низці країн Африки
23 березня, 2024 02:20

Многие люди до сих пор считаются пропавшими без вести
7 травня, 2023 14:59

По словам специалистов, лава пока из вулкана не течет наружу, однако наблюдается рост сейсмической активности
7 сiчня, 2022 02:24

Понад 50 жінок стали жертвами насильства
2 жовтня, 2021 05:47

«Мисливці на відьом» звинуватили понад 300 жінок у причетності до «чаклунства»
29 вересня, 2021 17:40

Китай поступово реформує свою сувору політику щодо народжуваності
31 травня, 2021 16:16

Виверження загрожує знищенням популяції гірських горил
29 травня, 2021 18:49

У пайоні виверження зафіксовано випадки мародерства та спроби втеч із тюрем
23 травня, 2021 20:23

Військові на базі перебувають в режимі очікування на випадок повторної евакуації
23 травня, 2021 15:50

Причина трагічної загибелі Олександра Мулявка не повідомляється
21 сiчня, 2021 13:15

В Мбандаке зафиксировано четыре смертельных случая
1 червня, 2020 19:28
В Демократичній Республіці Конго планували оголосити про припинення спалаху
13 квiтня, 2020 16:45

Хворі прибули з Парижа і Мілана
15 березня, 2020 08:50

Полиция применила оружие, в результате чего двое протестующих были убиты
26 листопада, 2019 17:44

200 людей считаются пропавшими без вести
27 травня, 2019 10:51

Несколько вагонов перевернулись, еще несколько упали с моста в реку
18 березня, 2019 07:47

Дільниці відкриті в 72 країнах світу
28 лютого, 2019 14:19

В далекой Африке также вспомнили об исторической для Украины дату
23 сiчня, 2019 16:30

Президентские выборы в ДРК должны были состояться два года назад, однако нынешний правитель страны Кабила отказывался покидать пост президента
10 сiчня, 2019 11:08

Протесты начались после того, как избирательная комиссия страны из-за вспышки Эболы исключила города Бени, Бутембо и их окрестности из голосования на президентских и парламентских выборах
27 грудня, 2018 17:40
